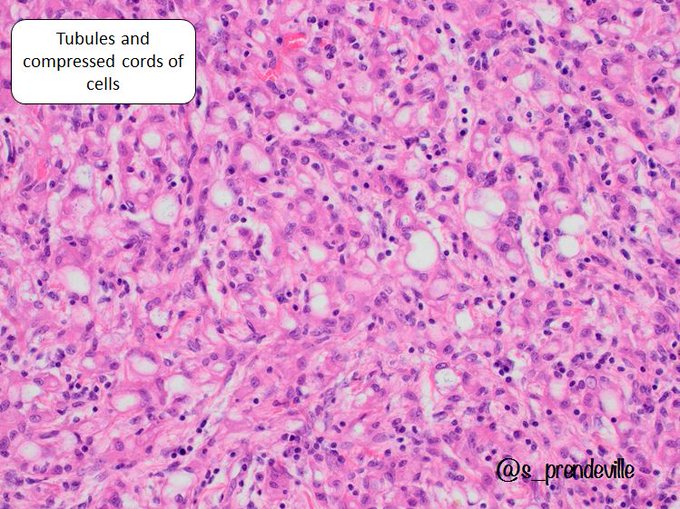

testisのTwitterイラスト検索結果。 28 件
Vandaag is Johann Jakob Scheuchzer jarig, deze Zwitsers arts en natuuronderzoeker zou vandaag 350 jaar geworden zijn! Hij is bekend om zijn Homo Dilivii Testis, het fossiel van een Reuzensalamander dat hij hield voor een afdruk van een mens die de zondvloed zou hebben gezien.
Sissy Blakely: Flaming Bombshell
#JohnnyTest
#JohnnyTestFanart
#JohnnyTestArt
#JohnnyTestIsBack
#SissyBlakely
#Sissy
#Blakely
#Teletoon
#CartoonNetwork
#Fanart
#CartoonFanart
#Cartoon
#Cartoons
#CartoonGirl
#CartoonGirls
#CanadianCartoons
SEE MORE ► https://t.co/xANZwktzHt
HIDUP MATI GOES TO CF15 🔥🔥🔥
B59-ab. DAY 1 ONLY.
me, moji @naotopasming and disong @mgwnsong bakal menggoyang panggung comifuro.
bawa banyak doujin tokrep dan merchandise tokrep lainnya yg tidak kalah fantestis ✨🕺.
MAMPIR YA GAEZ, BLEH JAJAN BLEH FOTO BARENG KITA UHUY 🤸
Julian Testis Whitmore is an unlockable opponent in Vs. Whitty Definitive Edition. He was originally going to be a retelling of the OG Whitty. FNF cursor with fanart Julian Testis Whitmore. #CustomCursor #Cursor #fanart #fnf #Whitty #fridaynightfunkin
https://t.co/umWu4Rspci
Don't mind me... Just sittin' here waiting for #JohnnyTest season 8...
Johnny Test season 8 is tomorrow!
#Season8
#JohnnyTestIsBack
#JohnnyTestSeason7
#WildBrain
#Netflix
#NetflixNews
#NetflixAndChill
#NetflixRevival
#Cartoon
#Cartoons
#CartoonMemes
#CartoonNews
#TLB
@trigeminy_henry @ICH8412 @sono_sam Interesting, thanks. I had to google appendix testis 🤦
Brain and testis: more alike than previously thought? 'An association of intelligence with some semen quality parameters has been reported and a relation between dysfunctions of the human brain and testis has also been evident.' New review in #OpenBiology https://t.co/IyQP5vb8Pc
Testis, young adult
Tumour markers: normal
#GUpath #PediPath #pathtwitter #surgpath
@AREAJULID Nitip
open commis start from 10k/kepala dan free text ... bisa cek testi ku juga # testisujksalart yang berminat bisa DM yaa
@radenrauf Nitip
open commis start from 10k/kepala dan free text ... bisa cek testi ku juga # testisujksalart yang berminat bisa DM yaa
@widyHadid HMM MINYISIL
Nitip
open commis start from 10k/kepala dan free text ... bisa cek testi ku juga # testisujksalart yang berminat bisa DM yaa
contohnya gini bisa liat testi juga yaaa #testisujksalart
🔬 Adenomatoid tumour
➡️ Adrenal gland = rare but well-described site
I thought the gross image was interesting as at a more common site (eg paratestis) probably everyone would guess adenomatoid
➡️well-circumscribed mass, tan/yellow solid cut surface
ctd👇